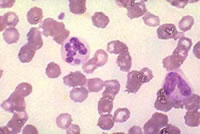

Edukativni članci
18.04.2014
OSPICE, MORBILI
 Ospice su vrlo zarazna respiratorna bolest uzrokovana virusom morbila. Ospice su vrlo zarazna respiratorna bolest uzrokovana virusom morbila.
Počinje s povišenom temperaturom, kašljem, curenjem nosa, upalom očnih spojnica i crvenilom očiju, upalom grla, općom slabosti i pojavom Koplikovih pjega na sluznici usta (sitne bijele pjege). Nakon 3-5 dana, uz porast temperature do vrhunca od 40°C, javlja se crveni osip. Prvo je vidljiv iza ušiju i uz granicu kose na čelu, zatim po licu, vratu, trupu i na kraju na udovima. Nakon 3-4 dana osip blijedi istim redoslijedom kojim je izbijao.
Iako opisana klinička slika ne djeluje osobito teška, ova je bolest zabrinjavajuća jer u oko 30% oboljelih nastaju komplikacije.
Jedno od 10-ero oboljele djece razvije upalu uha koja može dovesti do trajne gluhoće, jedno od 20-ero djece razvije upalu pluća koja u male djece može dovesti do smrti. Jedno od 1000 oboljele djece dobije upalu mozga (encefalitis) s konvulzijama a kao posljedica može ostati mentalna retardacija. Jedno do dvoje od 1000 oboljele djece umire. Kod trudne žene koja oboli od ospica može doći do pobačaja ili prijevremenog poroda...
Opširnije
11.04.2014
PREVENCIJA BJESNOĆE
 U Hrvatskoj je prisutan takozvani silvatični oblik bjesnoće, što znači da su glavni rezervoar ove bolesti divlje životinje. Kod nas je to prvenstveno lisica. Godišnji broj lisica pozitivnih na bjesnoću kreće se od 300-700. Ostale divlje životinje su znatno rjeđe pozitivne.
Povremeno se bjesnoća javi i u domaćih životinja, osobito pasa i mačaka, jer ulaze u stanište lisice te se u kontaktu s njom zaraze. Broj domaćih životinja pozitivnih na bjesnoću kreće se od 30-80 godišnje. U Hrvatskoj je prisutan takozvani silvatični oblik bjesnoće, što znači da su glavni rezervoar ove bolesti divlje životinje. Kod nas je to prvenstveno lisica. Godišnji broj lisica pozitivnih na bjesnoću kreće se od 300-700. Ostale divlje životinje su znatno rjeđe pozitivne.
Povremeno se bjesnoća javi i u domaćih životinja, osobito pasa i mačaka, jer ulaze u stanište lisice te se u kontaktu s njom zaraze. Broj domaćih životinja pozitivnih na bjesnoću kreće se od 30-80 godišnje.
Na cijelom teritoriju Hrvatske, osim jadranskih otoka, javlja se bjesnoća u životinja, a najveća učestalost je na području Zagrebačke, Krapinsko-Zagorske, Sisačko-Moslavačke, Karlovačke, Koprivničko-Križevačke, Bjelovarsko-Bilogorske i Splitsko-Dalmatinske županije.
Postoji više razina na kojima se može provoditi prevencija bjesnoće. Jedan od temeljnih postupaka je smanjenje broja bolesnih i zaraženih životinja koje su izvor zaraze za okolinu. S obzirom da su glavni rezervoar u prirodi lisice, od 2011.g. provodi se oralna vakcinacija lisica. Tom akcijom koja se provodi dva puta godišnje, u proljeće i jesen, imuniziraju se (cijepe) lisice i njihov pomladak. Iz zrakoplova se u ruralna područja cijele hrvatske ispuštaju mamci koji u sebi sadrže cjepivo u plastičnom spremniku...
Opširnije
04.04.2014
BJESNOĆA, RABIES
 Bjesnoća je zarazna bolest uzrokovana virusom iz porodice Lyssavirusa. Jedina je zarazna bolest koja redovito završava smrtno ukoliko se pojave simptomi. To je zoonoza, dakle bolest koja se prenosi sa životinje na čovjeka. Bjesnoća je zarazna bolest uzrokovana virusom iz porodice Lyssavirusa. Jedina je zarazna bolest koja redovito završava smrtno ukoliko se pojave simptomi. To je zoonoza, dakle bolest koja se prenosi sa životinje na čovjeka.
Rezervoar virusa su divlje i domaće životinje sisavci: lisice, vukovi, psi, mačke a u nekim zemljama i šišmiši.
Prijenos virusa se ostvaruje ugrizom ili direktnim kontaktom sa slinom bolesne životinje. Ogrebotine, sitne ili veće otvorene rane na koži predstavljaju ulazna vrata za virus ali najveći je rizik od ugriza bijesne životinje. Dokazani su i drugi načini prijenosa kao kontaminacija sluznica oka, nosa i usta, aerosolom od šišmiša, transplantacijom rožnice ili drugih organa i tkiva. Ovakvi načini prijenosa su više izuzetak nego pravilo...
Opširnije
27.03.2014
ERLIHIOZA
Erlihioza je zajedničko ime za nekoliko bakterijskih bolesti koje pogađaju ljude i životinje. Erlihioza je zajedničko ime za nekoliko bakterijskih bolesti koje pogađaju ljude i životinje.
Ljudsku erlihiozu uzrokuju tri vrste erlihija: Ehrlichia chaffeensis, Ehrlichia ewingii i Ehrlichia muris.
Ovu bolest na čovjeka prenose zaraženi krpelji.
1-2 tjedna nakon uboda javljaju se povišena temperatura, glavobolja, zimica, malaksalost, bolovi u mišićima, mučnina/povraćanje/proljev, konfuzija, crvenilo očiju, ponekad ospi. Ne moraju biti izraženi svi simptomi, već njihove različite kombinacije koje variraju ud pacijenta do pacijenta. Osip nije redovna pojava kod erlihioze, javlja se u oko 60% djece i 30% odraslih.
Ovo je ozbiljna bolest koja može završiti fatalno ako se ne započne s liječenjem na vrijeme...
Opširnije
21.03.2014
LYME BORELIOZA
 Lyme borelioza je zarazna bolest uzrokovana bakterijom Borrelia borgdorferi. Na ljude se prenosi ubodom zaraženog krpelja. Lyme borelioza je zarazna bolest uzrokovana bakterijom Borrelia borgdorferi. Na ljude se prenosi ubodom zaraženog krpelja.
Karakteristični simptomi su visoka temperatura, glavobolja, umor te osip na koži koji se naziva erythema migrans. Ukoliko se bolest ne liječi u ovoj ranoj fazi, infekcija se širi na zglobove, srce i živčani sustav.
3-30 dana nakon uboda krpelja na samom mjestu uboda u 80% zaraženih ljudi javlja se crvenilo prstenastog oblika (EM- erythema migrans) koje se širi do čak 30 cm u promjeru, koža u sredini prstena ostaje blijeda. Ova kožna promjena ne svrbi, ne boli ali je lagano uzdignuta i topla.
Kod nekih osoba uz osip javlja se i visoka temperatura, umor, glavobolja, bolovi u mišićima i zglobovima te otok limfnih čvorova...
Opširnije
13.03.2014
O KRPELJIMA
 Krpelji su sitni kukci koji spadaju u skupinu paučnjaka. Veliki su 1-5 mm ovisno o fazi razvoja u kojoj se nalaze: jajašce, ličinka, nimfa i adult. Nakon što se jajašca izlegu sve razvojne forme moraju sisati krv da bi mogle preživjeti i prijeći u slijedeći razvojni oblik. Da bi došli do krvi krpelji moraju naći domaćina pa je ponekad potrebno i tri godine da bi završili svoj razvojni ciklus, tj. da bi došli do faze adulta kad odrasla ženka polaže jajašca. Krpelji su sitni kukci koji spadaju u skupinu paučnjaka. Veliki su 1-5 mm ovisno o fazi razvoja u kojoj se nalaze: jajašce, ličinka, nimfa i adult. Nakon što se jajašca izlegu sve razvojne forme moraju sisati krv da bi mogle preživjeti i prijeći u slijedeći razvojni oblik. Da bi došli do krvi krpelji moraju naći domaćina pa je ponekad potrebno i tri godine da bi završili svoj razvojni ciklus, tj. da bi došli do faze adulta kad odrasla ženka polaže jajašca.
Mnogi krpelji ugibaju zato što nisu uspjeli pronaći domaćina za sisanje krvi no to se kompenzira velikim brojem jajašaca koja polaže zrela ženka.
Domaćini mogu biti sisavci, ptice, reptili i vodozemci...
Opširnije
04.03.2014
KRPELJNI MENINGOENCEFALITIS
 Krpeljni meningoencefalitis (KME) je virusna zarazna bolest koja zahvaća centralni živčani sustav a javlja se u Europi i Aziji. Krpeljni meningoencefalitis (KME) je virusna zarazna bolest koja zahvaća centralni živčani sustav a javlja se u Europi i Aziji.
Nakon uboda zaraženog krpelja i inkubacije od 7-14 dana razvija se bolest karakterizirana s dvije faze. Prva faza traje 2-4 dana s nespecifičnim simptomima kao što su visoka temperatura, slabost, bolovi u mišićima, glavobolja, gubitak apetita, ponekad mučnina i povraćanje. Zatim nastupa remisija u trajanju od 8 dana, da bi uslijedila druga faza bolesti kad se javljaju simptomi od strane središnjeg živčanog sustava. To mogi biti meningitis (povišena temperatura, glavobolja, zakočenost vrata), encefalitis (vrtoglavica, smetenost, vidni i duševni poremećaji, motorički ispadi i paralize) ili meningoencefalitis. Bolest je težeg tijeka u odraslih nego u djece. U 2/3 osoba zaraženih ovim virusom razvije se samo prva faza bolesti, a u preostale trećine obje faze bolesti s izraženim neurološkim simptomima.
Oporavak može biti dug, neurološke posljedice ostaju u 30-60% slučajeva kroz duži period, ponekad trajno. Moguć je i smrtni ishod u 1-2% oboljelih a nastupa obično 5-7 dana nakon pojave neuroloških simptoma.
Dijagnoza se postavlja na temelju simptoma, epidemioloških podataka i potvrdnih seroloških testova.
Specifičnog lijeka na žalost nema. Na raspolaganju je hospitalizacija i primjena simptomatskih lijekova (protuupalni lijekovi, kortikosteroidi)...
Opširnije
25.02.2014
KAMPILOBAKTERIOZA
 Kampilobakterioza je zarazna bolest uzrokovana bakterijom iz porodice Campylobacter. U razvijenoj bolesti simptomi su proljev, grčevi u trbuhu uz jake bolove i visoku temperaturu, često podsjeća na upalu slijepog crijeva. Proljev može biti krvav, praćen mučninom i povraćanjem. Simptomi se javljaju 2-5 dana nakon zaražavanja a bolest traje oko 7 dana. U nekih zaraženih ne razvije se bolest, dok s druge strane u osoba oslabljenog imuniteta bakterija može ući u krvni optok te uzrokovati teško, po život opasno stanje. Kampilobakterioza je zarazna bolest uzrokovana bakterijom iz porodice Campylobacter. U razvijenoj bolesti simptomi su proljev, grčevi u trbuhu uz jake bolove i visoku temperaturu, često podsjeća na upalu slijepog crijeva. Proljev može biti krvav, praćen mučninom i povraćanjem. Simptomi se javljaju 2-5 dana nakon zaražavanja a bolest traje oko 7 dana. U nekih zaraženih ne razvije se bolest, dok s druge strane u osoba oslabljenog imuniteta bakterija može ući u krvni optok te uzrokovati teško, po život opasno stanje.
Campylobacter je glavni uzrok proljeva u SAD i zemljama EU, učestaliji je od salmonele.U Hrvatskoj još uvijek je vodeći uzročnik proljeva salmonela no iz godine u godinu osjetno raste učestalost kampilobakterioza...
Opširnije
21.02.2014
STAFILOKOKNO TROVANJE HRANOM
 Staphylococcus aureus ili zlatni stafilokok je bakterija koja povremeno naseljava kožu oko noktiju i izlazni dio nosa. Može se naći u oko 25% zdravih ljudi. Staphylococcus aureus ili zlatni stafilokok je bakterija koja povremeno naseljava kožu oko noktiju i izlazni dio nosa. Može se naći u oko 25% zdravih ljudi.
Luči toksin koji može dovesti do trovanja hranom. Najčešći način na koji stafilokok zagadi hranu je kontaktom kliconoše (osoba koja nosi klice zarazne bolesti a nema simptome bolesti) s hranom.
Stafilokok je otporan na sol pa se može razmnožavati i u slanoj hrani, na primjer šunki. Odgovaraju mu sobne temperature na kojima se razmnožava i proizvodi toksin kojeg nije moguće uništiti kuhanjem, za razliku od same bakterije koja propada pri visokim temperaturama. Primjeri hrane koja može uzrokovati stafilokokno trovanje su: mljeveno meso, puding i druge slastice, sendviči. Najrizičnija je ona hrana koja se priprema rukama a ne zahtijeva kuhanje...
Opširnije
13.02.2014
NOROVIRUSNA TROVANJA HRANOM
 Norovirus je vrlo zarazan. Svatko se može njime zaraziti, čak i više puta tokom života jer postoji više različitih tipova norovirusa. Norovirus je vrlo zarazan. Svatko se može njime zaraziti, čak i više puta tokom života jer postoji više različitih tipova norovirusa.
Izvor zaraze je bolestan čovjek koji izlučuje virus stolicom, najviše u toku bolesti ali i do 2 tjedna nakon ozdravljenja. Ukoliko mala količina stolice ili povraćenog sadržaja bolesne osobe dođe u usta zdrave osobe razvit će se bolest. To se događa češće no što želimo vjerovati, uglavnom preko hrane i vode zagađene norovirusom, dodirivanjem površina ili predmeta kontaminiranih virusom pa stavljanjem prstiju u usta, ili kontaktom sa zaraženom osobom...
Opširnije
Stranica: 3 od 4 | 1 | 2 | 3 | 4 | |
Izdvajamo iz službe:
CORONAVIRUSU

Zadnji članci iz službe:
Zadnje novosti iz službe:
|
|
 Zavod za javno zdravstvo Sveti Rok
Zavod za javno zdravstvo Sveti Rok Zavod za javno zdravstvo Sveti Rok
Zavod za javno zdravstvo Sveti Rok





